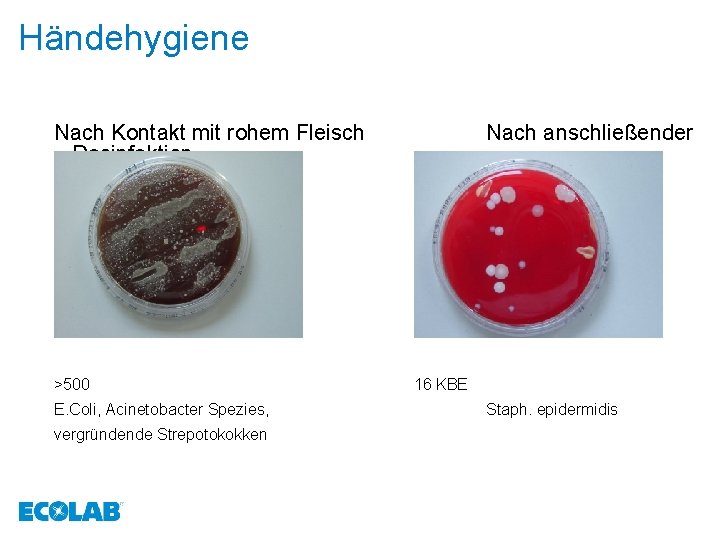
Händehygiene Nach Kontakt mit rohem Fleisch Desinfektion >500 E. Coli, Acinetobacter Spezies, vergründende Strepotokokken
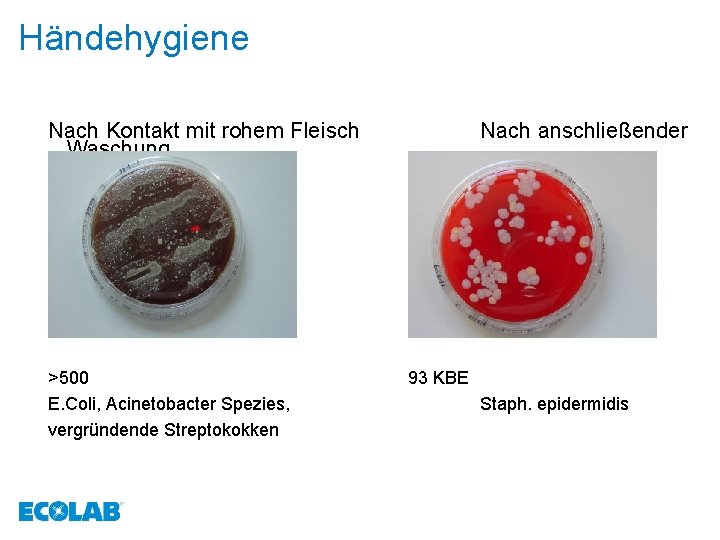
Händehygiene Nach Kontakt mit rohem Fleisch Waschung >500 E. Coli, Acinetobacter Spezies, vergründende Streptokokken
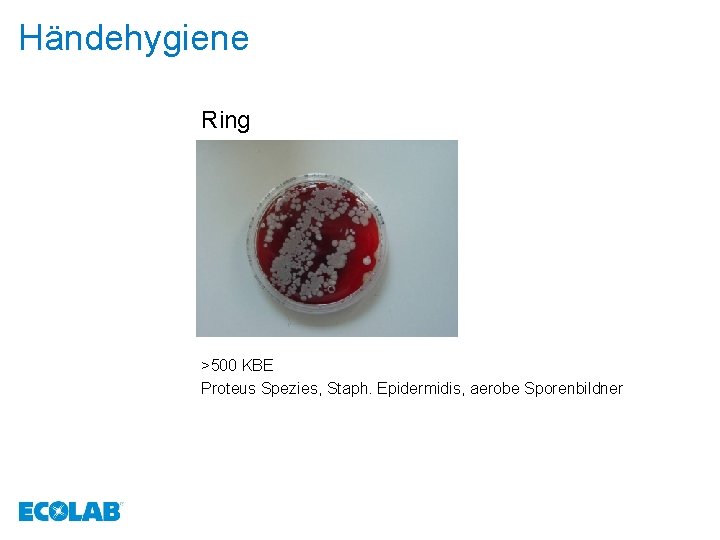
Händehygiene Ring >500 KBE Proteus Spezies, Staph. Epidermidis, aerobe Sporenbildner

Hygienemanahmen aus der Sicht eines Mikroorganismus Warum sich




























- Slides: 28

Hygienemaßnahmen aus der Sicht eines Mikroorganismus Warum sich Mikroorganismen nicht an Gesetze halten oder wie Mikroorganismen ticken oder warum reinigen allein nicht aussreicht.

Hygiene y Unter Hygiene versteht man alle Maßnahmen die zur Gesunderhaltung des Menschen dienen. Diese werden unterteilt in: 1. Dispositionsprophylaxe 2. Expositionsprohylaxe

Hygiene Dispositionsprophylaxe Hierunter zählen alle Faktoren die den Menschen widerstandsfähiger Machen gegen die Entstehung von Krankheiten. 1. Impfung 2. Ernährung 3. Lebensweise

Hygiene Expositionsprophylaxe Hierunter versteht man alle Maßnahmen zur Abwehr von äußeren Einflüssen. 1. Desinfektion 2. Sterilisation 3. Isolierung

SOLANGE NICHTS PASSIERT IST ALLES GUT Aber was ist wenn: Der Lebensmittelunternehmer muss den Nachweis erbringen das er sich an alle Gesetzte, Richtlinien und Verordnungen gehalten und auch diese überwacht hat. Dies ist nur möglich durch eine für den Betrieb erstelltes Hygienekonzept und die Umsetzung durch geschultes und verantwortungsvolles Personal. Hygiene reduziert das Haftungsrisiko.

Was wiegt ein Mensch im Durchschnitt Mann 82, 4 Kg bei einer Durchschnittsgröße von 178 cm Frau 67, 5 Kg bei einer Durchschnittsgröße von 165 cm

Sammelorte vom Mikroorganismen am menschlichen Körper y 1. 000 Bakterien in 1 ml. Speichel y 50. 000 Bakterien auf der Haut y 100. 000 Bakterien im Verdauungstrakt Der Mensch hat 75 Billionen Körperzellen aber 750 Billionen Bakterien

Bakterienformen

Bakterienformen

Was braucht der Mensch zum Leben 1. Feuchtigkeit (der Mensch besteht zu 70% aus Wasser) 2. Nahrung 3. Wärme 4. Sauerstoff 5. p. H-wert 6. Ruhe 7. Platz 8. Fortpflanzungsmöglichkeit

Was brauchen Bakterien zum Leben 1. Feuchtigkeit 2. Nahrung 3. Wärme 4. Sauerstoff * 5. p. H-wert 6. Ruhe 7. Platz 8. Fortpflanzungsmöglichkeit

Vermehrung durch Zweiteilung. . . geht unter optimalen Bedingungen sehr schnell Hoffentlich weiß hier keiner, dass ich eine Salmonelle bin. . . 20 min 40 min 60 min

Viren

Unbehülltes Virus Behülltes Virus behülltes Virus

Wie vermehren sich Viren? Durch Replikation y Adsorption y Penetration y Uncoating y Biosynthese y Maturation y Freisetzung

HAV im Stuhl 1012 -1014 Viruspartikel/g Stuhl 1 Pfund Bodensee pro Liter ca. 5 -10 Viruspartikel

Warum ticken Mikroorgansimen anders? y 7 + 8 = 15 y 9 – 6=3 y 4 : 2=2 y 3 x 3=9 y 6 + 6 = 13 y 2 x 2=4 y 12 x 12 = 144

Gedankengänge Mensch vs. Keim Wieso Händehygiene, waschen reicht doch !? Wieso Desinfektion ? Wieso Schmuck ablegen ? 65° ist doch viel zu heiß ! Verarbeite ch heute Fisch, Geflügel, Hackfleisch? Super, wieder einer die Hände nur wäscht Super, der reinigt nur… Super, Schmuck da kann ich mich verstecken 40°C genau meine Temperatur Tolle Speisekarte heute

Die 10 häufigsten Lebensmittelvergiftungen y mangelhaftes y Speisen Abkühlen und Kühllagern von Speisen zu lange vorher zubereitet y mangelhafte y Infiziertes Heißhaltung von Speisen Personal im Umgang mit Lebensmittel y unzureichendes y schlechte Aufwärmen von Speisen Gerätehygiene und allgemeine Hygienemängel y Verwendung von Essenresten y Kreuzkontamination y unzureichendes y Kontaminierte Erhitzen von Speisen Rohlebensmittel y Hygienemängel beim Zulieferer

Dabei ist Hygiene keine Hexerei Allein durch eine richtig durchgeführte Händehygiene lassen sich die meisten Keime viele Lebensmittelvergiftungen verhindern.

Händehygiene Lebensmittelhygieneverordnung § 3 Allgemeine Hygieneanforderungen Lebensmittel dürfen nur so hergestellt, behandelt oder in den Verkehr gebracht werden, daß sie bei Beachtung der im Verkehr erforderliche Sorgfalt der Gefahr einer nachteiligen Beeinflussung nicht ausgesetzt sind. Kapitel 1 Absatz 4 Für Handwaschbecken muss eine Warm- und Kaltwasserzufuhr vorhanden sein. Darüber hinaus müssen Mittel zum hygienischen Reinigen und Trocknen der Hände vorhanden sein.
Händehygiene Nach Kontakt mit rohem Fleisch Desinfektion >500 E. Coli, Acinetobacter Spezies, vergründende Strepotokokken Nach anschließender 16 KBE Staph. epidermidis
Händehygiene Nach Kontakt mit rohem Fleisch Waschung >500 E. Coli, Acinetobacter Spezies, vergründende Streptokokken Nach anschließender 93 KBE Staph. epidermidis
Händehygiene Ring >500 KBE Proteus Spezies, Staph. Epidermidis, aerobe Sporenbildner

katholische & evangelische Händedesinfektion

Händedesinfektion

Hygiene Der bösen Taten gutes Ende: Man wäscht in Unschuld sich die Hände Der wahre Weise bleibt da skeptisch Auch Unschuld ist nicht antiseptisch Eugen Roth

Vielen Dank für Ihre Aufmerksamkeit!